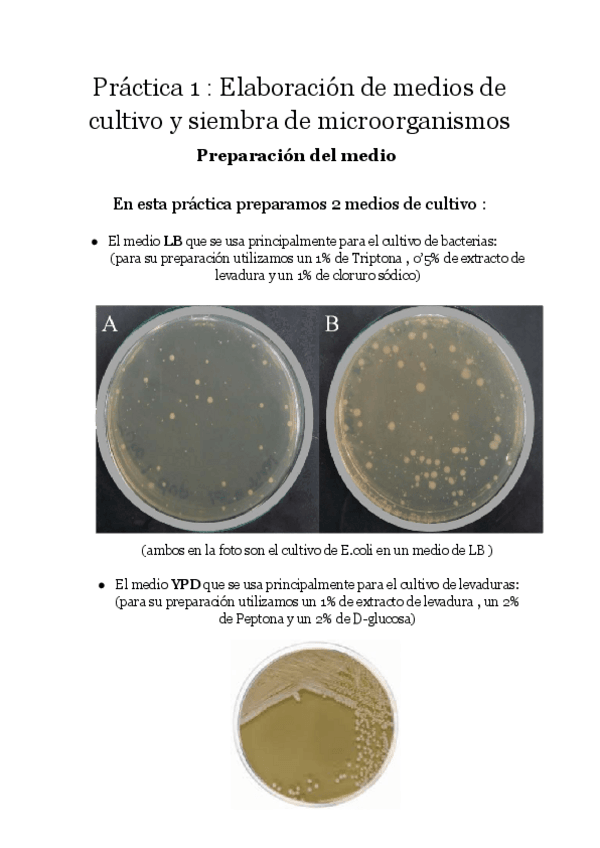

@mborrellcau
23 Publicaciones
857 Interacciones
16 Seguidores
3 Siguiendo
Lista de publicaciones de mborrellcau
He publicado nuevos examenes de 1º Zoología y Botánica: Preguntas-Botanica.pdf
He publicado nuevos trabajos de 1º Física: INFORME-PRACTICA-FISICA.pdf
He publicado nuevos apuntes de 1º Matemáticas: Cuestionario-evaluable-Algebra.pdf
He publicado nuevos examenes de 1º Geología: Examen-de-mapas-geologia-2024-resuelto.pdf
He publicado nuevos examenes de 1º Geología: Preguntas-test-de-geologia.pdf
He publicado nuevos apuntes de 1º DERECHO PÚBLICO DEL MEDIO AMBIENTE: Derecho-penal.pdf
practicas
-
Practicas completas de micro kiko
He publicado nuevos practicas de 1º Microbiología: Practicas completas de micro kiko
He publicado nuevos trabajos de 1º Zoología y Botánica: Trabajo-Fotografico2024.pdf
He publicado nuevos apuntes de 1º Física: Apuntes-para-practica-1-Fisica.pdf
He publicado nuevos apuntes de 1º Geología: Apuntes-para-visu-de-minerales.pdf
He publicado nuevos apuntes de 1º Geología: visu-de-minerales-2023-.pdf
He publicado nuevos trabajos de 1º DERECHO PÚBLICO DEL MEDIO AMBIENTE: trabajo-de-jurisprudencia.pdf
He publicado nuevos apuntes de 1º DERECHO PÚBLICO DEL MEDIO AMBIENTE: Practica-pelicula-Erin-brockovich.pdf
He publicado nuevos apuntes de 1º Geología: Apuntes-Para-Mapa-Topografico.pdf
He publicado nuevos apuntes de 1º Matemáticas: sistemas-de-ecuaciones.pdf
He publicado nuevos apuntes de 2º Matemáticas II: puntos-rectas-y-planos.pdf
He publicado nuevos apuntes de 1º Matemáticas I: 2021repasoderivadas.pdf